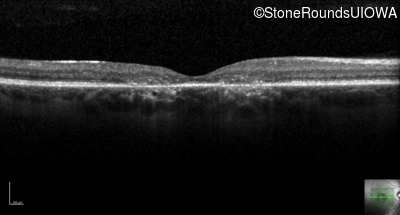
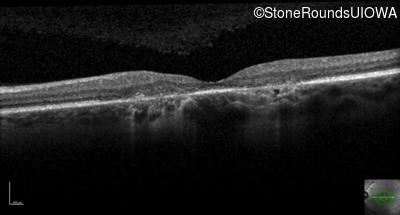

Case
SR688
Student Mode
XL Cone and Cone Rod Dystrophy (IA1bi)
Male
Male
Hidden
SR688
Student Mode
XL Cone and Cone Rod Dystrophy (IA1bi)
Male
Male
Highlighted Images
| Age at visit: 28 years | OD | OS |
|---|---|
History
This 28 year old man has recently noticed some difficulty with fine visual tasks such as tying a fishing lure to a fishing line.
| Age at visit: 35 years |
| OD | OS | ||
|---|---|---|---|
| Age at visit: 40 years |
| OD | OS | ||
|---|---|---|---|
| OD | OS | ||
|---|---|---|---|
| OD | OS | ||
|---|---|---|---|
Diagnosis & molecular findings
| Disease | Gene | Allele 1 variant(s) | Allele 2 variant(s) | Inheritance mode |
|---|---|---|---|---|
| XL Cone and Cone Rod Dystrophy | RPGR | Glu1031 del1gA | XL |
Disease:
Gene:
Allele 1:
Glu1031 del1gA
Allele 2:
Inheritance:
XL